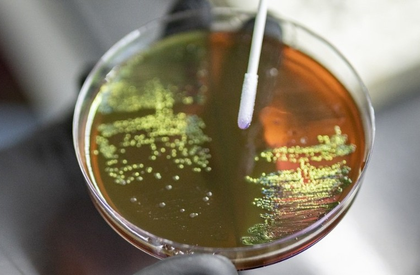
Early action on AMR key to ensure infections remain treatable, surgeries stay safe: WHO  | Early action on AMR key to ensure infections remain treatable, surgeries stay safe: WHO

Early action on AMR key to ensure infections remain treatable, surgeries stay safe: WHO
By IANS | Updated: November 21, 2025 17:45 IST2025-11-21T17:44:50+5:302025-11-21T17:45:20+5:30
New Delhi, Nov 21 Early action against the rising antimicrobial resistance (AMR) is needed to ensure infections remain ...
Early action on AMR key to ensure infections remain treatable, surgeries stay safe: WHO
New Delhi, Nov 21 Early action against the rising antimicrobial resistance (AMR) is needed to ensure infections remain treatable, and surgeries stay safe, said the World Health Organization (WHO), during the World AMR Awareness Week, on Friday.
The WHO urged countries, specifically in the South-East Asia, to “Act Now: Protect Our Present, Secure Our Future.”
“AMR threatens the very foundations of modern medicine, jeopardising decades of medical progress, as around the world -- and particularly in South-East Asia -- common infections are becoming harder to treat,” said Dr Catharina Boehme, Officer-in-Charge, WHO South-East Asia.
“It is already claiming lives, undermining essential treatments, and placing enormous strain on health systems. Antimicrobial resistance is already resulting in over a million deaths each year worldwide, with the burden expected to rise sharply in the coming decades unless urgent action is taken,” Boehme added.
The recent Global Antimicrobial Resistance Surveillance Report 2025 documents the disproportionate effects of antibiotic resistance in low- and middle-income countries, and those with weaker health systems.
Alarmingly, in 2023, resistance was most frequent in Southeast Asia and the Eastern Mediterranean regions.
“The South-East Asia Region faces distinctive challenges, including diverse health systems, varying levels of access to medicines, and unique patterns of antimicrobial usage. In responding to these, we have opportunities for innovation and leadership through fostering regional partnerships, investing in laboratory capacity, and supporting community-based initiatives,” Boehme said.
Meanwhile, the Regional Roadmap on AMR in the South-East Asia Region (2025–2030) was endorsed by Member States at the Seventy-eighth Session of the WHO Regional Committee in October 2025.
It provides a clear framework to accelerate progress towards global AMR targets and strengthen country-led action. It emphasises stronger national leadership, integration within health priorities, sustainable financing, and improved governance.
“We must prioritise long-term investment and strategic action in the human, animal, and environmental health sectors. Strengthening surveillance, ensuring equitable access to quality medicines and diagnostics, fostering innovation, and building resilient systems all require long-term commitment and resources,” Boehme said.
Disclaimer: This post has been auto-published from an agency feed without any modifications to the text and has not been reviewed by an editor
Open in app